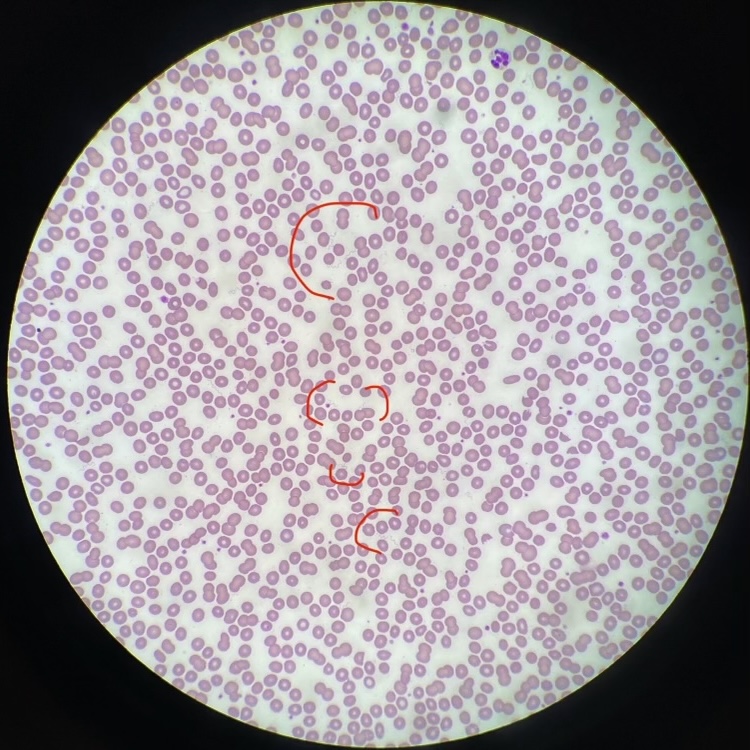

Case Presentation: A 67 year old patient (she/her) with mitral valve prolapse was admitted in mid-August for acute hypoxic respiratory failure. She was at baseline health until 14 days prior to admission, when she developed fever, malaise, and generalized weakness. Outpatient bloodwork revealed new pancytopenia (WBC 3.9 x 10^9/L, Plt 66 x 10^9/L, Hgb 11.2 g/dL), elevated inflammatory markers (CRP 29 mg/dL, ESR 44 mm/hr), and normal metabolic panel. Her symptoms improved 10 days prior to admission, and repeat labs from then showed improved leukopenia and thrombocytopenia. She remained well until 4 days before admission, when she had recurrence of symptoms and new nausea and non-bloody diarrhea. She presented to her outpatient physician, who found her to be volume depleted. She received 2 liters IV fluids but subsequently developed hypoxic respiratory failure, prompting presentation to the emergency room. She denied weight loss, night sweats, or chest pain. She started terbinafine 2 weeks prior to symptoms. Her only recent travel was to Lake Tahoe in eastern California roughly 3 weeks prior to symptoms. She recalled noticing insect bite marks on her shoulder on that trip but no rash. She works in a patient-facing role in an acute care hospital in northern California but otherwise denied sick contacts. In the emergency room, she was stabilized on 2 liters oxygen. Vitals otherwise were within normal limits. Labs were remarkable for continued anemia, recurrence of her thrombocytopenia and elevated inflammatory markers, new mixed liver enzyme elevations (ALT 93 U/L, AST 161 U/L, AP 253 U/L), and elevated lactic acid (4.3 mmol/L). Imaging showed bilateral pleural effusions, pancolitis, and mesenteric/periaortic lymphadenopathy. Blood smear was sent to evaluate for acute hematologic process and returned remarkable for circulating spirochetes, or loosely coiled spiral bacteria with relatively regular undulations, morphologically compatible with Borrelia species (Figures 1, 2). She was started on ceftriaxone, then transitioned to doxycycline to complete 14 days. She showed improvement in her symptoms and labs and was discharged home on hospital day 4. After discharge, Borrelia species PCR returned negative; however, Relapsing Fever PCR returned positive, confirming our diagnosis of Tick-Borne Relapsing Fever (TBRF).
Discussion: This case demonstrates severe sepsis in the setting of TBRF, which is caused by Borrelia bacteria typically transmitted by ticks and lice. The disease is characterized by a 4-21 day incubation period, followed by episodes of fever, malaise, and nausea/vomiting lasting ~3 days and separated by ~7 days of general wellness. In the US, it typically occurs in summer months in Texas and the mountainous areas of western states. Diagnosis can be confirmed by Relapsing Fever PCR, which tests for several Borrelia species (as opposed to the Borrelia species PCR, which mainly tests for B. burgdorferi and was negative for this patient). This case was notable for its marked systemic inflammatory presentation, particularly hypoxic respiratory failure (presumably in the setting of increased vascular permeability); literature suggests most patients with TBRF (55%) require hospitalization.
Conclusions: This patient demonstrated episodes of fevers and malaise typical of TBRF, with her presentation notable for systemic inflammation necessitating hospitalization. Prompt evaluation of her pancytopenia ultimately led to her diagnosis; she fortunately demonstrated improvement with appropriate therapy.